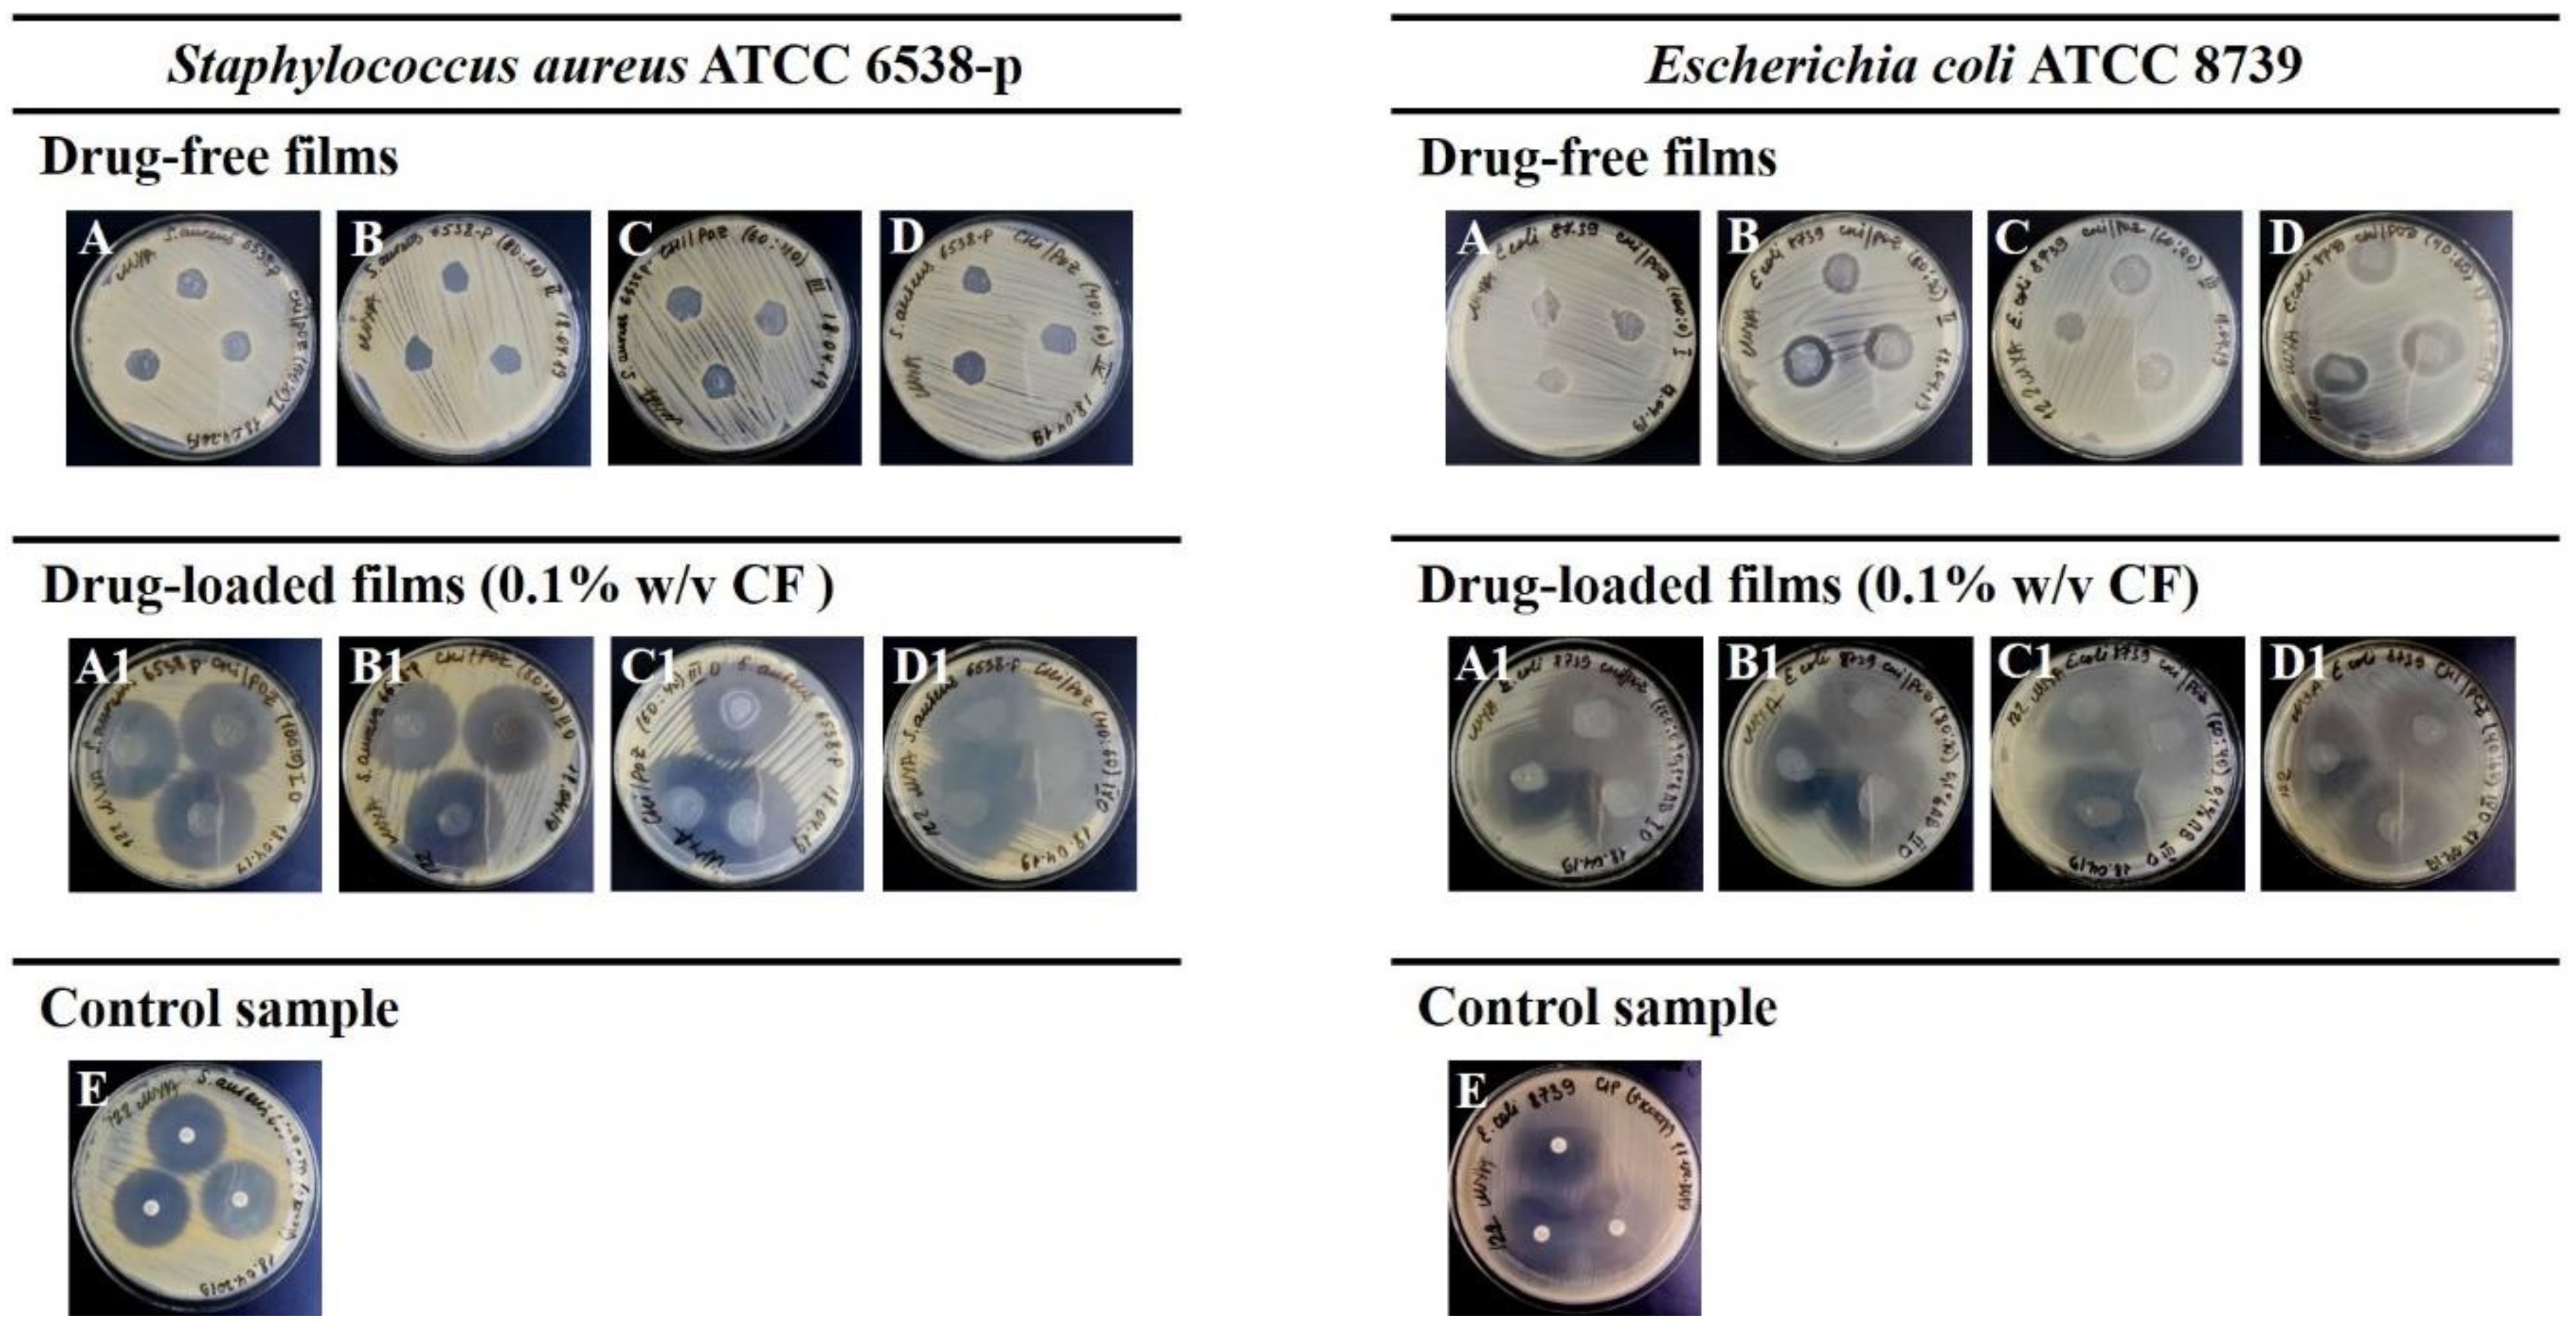
Materials 13 01709 g001 Materials 13 01709 g001

Chitosan/Poly(2-ethyl-2-oxazoline) Films with Ciprofloxacin for Application in Vaginal Drug Delivery
Abstract
1. Introduction
2. Materials and Methods
2.1. Materials
2.2. Preparation of Films
2.3. Preparation of Ciprofloxacin-Loaded Films
2.4. Characterisation of Films
2.4.1. Film Thickness and Weight
2.4.2. Folding Endurance
2.4.3. Surface pH Measurements
2.4.4. Transparency
2.5. Antimicrobial Studies
2.6. In Vitro Drug Release Experiments
2.7. Ex vivo Mucoadhesion Studies on Sheep Vaginal Tissue
2.8. Statistical Analysis
3. Results and Discussion
3.1. Preparation and Characterisation of Films
3.2. Antimicrobial Activity
3.3. In vitro Drug Release Studies
3.4. Ex Vivo Mucoadhesion Studies
4. Conclusions
Supplementary Materials
Author Contributions
Funding
Acknowledgments
Conflicts of Interest
References
- Hussain, A.; Ahsan, F. The vagina as a route for systemic drug delivery. J. Control. Release 2005, 103, 301–313. [Google Scholar] [CrossRef] [PubMed]
- Vermani, K.; Garg, S. The scope and potential of vaginal drug delivery. Pharm. Sci. Technol. Today 2000, 3, 359–364. [Google Scholar] [CrossRef]
- Das Neves, J.; Bahia, M. Gels as vaginal drug delivery systems. Int. J. Pharm. 2006, 318, 1–14. [Google Scholar] [CrossRef] [PubMed]
- Jensen, J.T. Vaginal ring delivery of selective progesterone receptor modulators for contraception. Contraception 2012, 87, 314–318. [Google Scholar] [CrossRef] [PubMed]
- Cook, M.; Brown, M.B. Polymeric gels for intravaginal drug delivery. J. Control. Release 2018, 270, 145–157. [Google Scholar] [CrossRef] [PubMed]
- Machado, R.M.; Palmeira-De-Oliveira, R.; Palmeira-De-Oliveira, A.; De Oliveira, J.M. Vaginal Films for Drug Delivery. J. Pharm. Sci. 2013, 102, 2069–2081. [Google Scholar] [CrossRef] [PubMed]
- Khutoryanskiy, V.V. Mucoadhesive Materials and Drug Delivery Systems; John Wiley & Sons, Ltd.: Chichester, UK, 2014. [Google Scholar]
- Cook, M.T.; Khutoryanskiy, V.V. Mucoadhesion and mucosa-mimetic materials—A mini-review. Int. J. Pharm. 2015, 495, 991–998. [Google Scholar] [CrossRef]
- Albarkah, Y.A.; Green, R.J.; Khutoryanskiy, V.V. Probing the mucoadhesive interactions between porcine gastric mucin and some water-soluble polymers. Macromol. Biosci. 2015, 15, 1546–1553. [Google Scholar] [CrossRef]
- Brannigan, R.; Khutoryanskiy, V.V. Synthesis and evaluation of mucoadhesive acryloyl-quaternized PDMAEMA nanogels for ocular drug delivery. Colloids Surfaces B: Biointerfaces 2017, 155, 538–543. [Google Scholar] [CrossRef]
- Jelkmann, M.; Menzel, C.; Baus, R.A.; Ausserhofer, P.; Baecker, D.; Gust, R.; Bernkop-Schnürch, A.; Ausserhofer, P. Chitosan: The One and Only? Aminated Cellulose as an Innovative Option for Primary Amino Groups Containing Polymers. Biomacromolecules 2018, 19, 4059–4067. [Google Scholar] [CrossRef]
- Jelkmann, M.; Leichner, C.; Menzel, C.; Kreb, V.; Bernkop-Schnürch, A. Cationic starch derivatives as mucoadhesive and soluble excipients in drug delivery. Int. J. Pharm. 2019, 570, 118664. [Google Scholar] [CrossRef] [PubMed]
- Sogias, I.A.; Williams, A.; Khutoryanskiy, V.V. Why is Chitosan Mucoadhesive? Biomacromolecules 2008, 9, 1837–1842. [Google Scholar] [CrossRef] [PubMed]
- Sahariah, P.; Másson, M. Antimicrobial Chitosan and Chitosan Derivatives: A Review of the Structure–Activity Relationship. Biomacromolecules 2017, 18, 3846–3868. [Google Scholar] [CrossRef] [PubMed]
- Ways, T.M.M.; Lau, W.M.; Khutoryanskiy, V.V. Chitosan and its derivatives for application in mucoadhesive drug delivery systems. Polymers 2018, 10, 267. [Google Scholar] [CrossRef] [PubMed]
- Luo, K.; Yin, J.; Khutoryanskaya, O.V.; Khutoryanskiy, V.V. Mucoadhesive and elastic films based on blends of chitosan and hydroxyethylcellulose. Macromol. Biosci. 2008, 8, 184–192. [Google Scholar] [CrossRef] [PubMed]
- Khoo, C. Oral gingival delivery systems from chitosan blends with hydrophilic polymers. Eur. J. Pharm. Biopharm. 2003, 55, 47–56. [Google Scholar] [CrossRef]
- Yeh, J.-T.; Chen, C.-L.; Huang, K.S.; Nien, Y.H.; Chen, J.L.; Huang, P.Z. Synthesis, characterization, and application of PVP/chitosan blended polymers. J. Appl. Polym. Sci. 2006, 101, 885–891. [Google Scholar] [CrossRef]
- Li, J.; Zivanovic, S.; Davidson, P.M.; Kit, K. Characterization and comparison of chitosan/PVP and chitosan/PEO blend films. Carbohydr. Polym. 2010, 79, 786–791. [Google Scholar] [CrossRef]
- Sizílio, R.; Galvão, J.; Trindade, G.; Pina, L.; Andrade, L.; Gonsalves, J.; Lira, A.A.M.; Chaud, M.V.; Alves, T.F.; Arguelho, M.; et al. Chitosan/pvp-based mucoadhesive membranes as a promising delivery system of betamethasone-17-valerate for aphthous stomatitis. Carbohydr. Polym. 2018, 190, 339–345. [Google Scholar] [CrossRef]
- Nakano, Y.; Bin, Y.; Bando, M.; Nakashima, T.; Okuno, T.; Kurosu, H.; Matsuo, M. Structure and Mechanical Properties of Chitosan/Poly(Vinyl Alcohol) Blend Films. Macromol. Symp. 2007, 258, 63–81. [Google Scholar] [CrossRef]
- Abraham, A.; Soloman, P.; Rejini, V. Preparation of Chitosan-Polyvinyl Alcohol Blends and Studies on Thermal and Mechanical Properties. Procedia Technol. 2016, 24, 741–748. [Google Scholar] [CrossRef]
- Hoogenboom, R. Poly(2-oxazoline)s: A Polymer Class with Numerous Potential Applications. Angew. Chem. Int. Ed. 2009, 48, 7978–7994. [Google Scholar] [CrossRef] [PubMed]
- Glassner, M.; Vergaelen, M.; Hoogenboom, R. Poly(2-oxazoline)s: A comprehensive overview of polymer structures and their physical properties. Polym. Int. 2017, 67, 32–45. [Google Scholar] [CrossRef]
- Policianova, O.; Brus, J.; Hruby, M.; Urbanova, M.; Zhigunov, A.; Kredatusova, J.; Kobera, L. Structural Diversity of Solid Dispersions of Acetylsalicylic Acid as Seen by Solid-State NMR. Mol. Pharm. 2014, 11, 516–530. [Google Scholar] [CrossRef]
- Fael, H.; Ràfols, C.; Demirel, A.L. Poly(2-Ethyl-2-Oxazoline) as an Alternative to Poly(Vinylpyrrolidone) in Solid Dispersions for Solubility and Dissolution Rate Enhancement of Drugs. J. Pharm. Sci. 2018, 107, 2428–2438. [Google Scholar] [CrossRef]
- Boel, E.; Smeets, A.; Vergaelen, M.; De La Rosa, V.R.; Hoogenboom, R.; Mooter, G.V.D. Comparative study of the potential of poly(2-ethyl-2-oxazoline) as carrier in the formulation of amorphous solid dispersions of poorly soluble drugs. Eur. J. Pharm. Biopharm. 2019, 144, 79–90. [Google Scholar] [CrossRef]
- Moustafine, R.I.; Viktorova, A.S.; Khutoryanskiy, V.V. Interpolymer complexes of carbopol® 971 and poly(2-ethyl-2-oxazoline): Physicochemical studies of complexation and formulations for oral drug delivery. Int. J. Pharm. 2019, 558, 53–62. [Google Scholar] [CrossRef]
- Abilova, G.K.; Kaldybekov, D.; Ozhmukhametova, E.K.; Saimova, A.Z.; Kazybayeva, D.S.; Irmukhametova, G.S.; Khutoryanskiy, V.V. Chitosan/poly(2-ethyl-2-oxazoline) films for ocular drug delivery: Formulation, miscibility, in vitro and in vivo studies. Eur. Polym. J. 2019, 116, 311–320. [Google Scholar] [CrossRef]
- Boateng, J.; Popescu, A. Composite bi-layered erodible films for potential ocular drug delivery. Colloids Surfaces B: Biointerfaces 2016, 145, 353–361. [Google Scholar] [CrossRef]
- Karki, S.; Kim, H.; Na, S.-J.; Shin, D.; Jo, K.; Lee, J. Thin films as an emerging platform for drug delivery. Asian J. Pharm. Sci. 2016, 11, 559–574. [Google Scholar] [CrossRef]
- Hallander, H.O.; Laurell, G. Identification of Cephalosporin-Resistant Staphylococcus aureus with the Disc Diffusion Method. Antimicrob. Agents Chemother. 1972, 1, 422–426. [Google Scholar] [CrossRef] [PubMed]
- Owen, D.H.; Katz, D.F. A vaginal fluid simulant. Contracept. 1999, 59, 91–95. [Google Scholar] [CrossRef]
- Mulu, W.; Yimer, M.; Zenebe, Y.; Abera, B. Common causes of vaginal infections and antibiotic susceptibility of aerobic bacterial isolates in women of reproductive age attending at Felegehiwot Referral Hospital, Ethiopia: A cross sectional study. BMC Women’s Heal. 2015, 15, 42. [Google Scholar] [CrossRef] [PubMed]
- Abdelkader, H.; Pierscionek, B.; Alany, R.G. Novel in situ gelling ocular films for the opioid growth factor-receptor antagonist-naltrexone hydrochloride: Fabrication, mechanical properties, mucoadhesion, tolerability and stability studies. Int. J. Pharm. 2014, 477, 631–642. [Google Scholar] [CrossRef]
- Hillery, A.M.; Lloyd, A.W.; Swarbrick, J. Drug Delivery and Targeting for Pharmacists and Pharmaceutical Scientists; CRC Press, Taylor & Francis: Boca Raton, FL, USA, 2001. [Google Scholar]
- Raafat, D.; Von Bargen, K.; Haas, A.; Sahl, H.-G. Insights into the Mode of Action of Chitosan as an Antibacterial Compound. Appl. Environ. Microbiol. 2008, 74, 3764–3773. [Google Scholar] [CrossRef]
- Raafat, D.; Sahl, H.-G. Chitosan and its antimicrobial potential – a critical literature survey. Microb. Biotechnol. 2009, 2, 186–201. [Google Scholar] [CrossRef]
- Alexander, N.J.; Baker, E.; Kaptein, M.; Karck, U.; Miller, L.; Zampaglione, E. Why consider vaginal drug administration? Fertil. Steril. 2004, 82, 1–12. [Google Scholar] [CrossRef]
- Lang, W.R. Vaginal acidity and pH. A review. Obstet. Gynecol. Surv. 1955, 10, 546–560. [Google Scholar] [CrossRef]
- Jalil, A.; Asim, M.H.; Le, N.-M.N.; Laffleur, F.; Matuszczak, B.; Tribus, M.; Bernkop–Schnürch, A. S-protected gellan gum: Decisive approach towards mucoadhesive antimicrobial vaginal films. Int. J. Boil. Macromol. 2019, 130, 148–157. [Google Scholar] [CrossRef]
- Davidovich-Pinhas, M.; Bianco-Peled, H. Mucoadhesion: A review of characterization techniques. Expert Opin. Drug Deliv. 2010, 7, 259–271. [Google Scholar] [CrossRef]
- Ruiz-Rubio, L.; Alonso, M.L.; Pérez-Álvarez, L.; Alonso, R.M.; Vilas, J.L.; Khutoryanskiy, V.V. Formulation of Carbopol®/Poly(2-ethyl-2-oxazoline)s mucoadhesive tablets for buccal delivery of hydrocortisone. Polymers 2018, 10, 175. [Google Scholar] [CrossRef] [PubMed]
- Sogias, I.A.; Williams, A.C.; Khutoryanskiy, V.V. Chitosan-based mucoadhesive tablets for oral delivery of ibuprofen. Int. J. Pharm. 2012, 436, 602–610. [Google Scholar] [CrossRef] [PubMed]

| Samples | Chemical Composition (% v/v) | Thickness (mm) | Weight (mg) | Folding Endurance | Transparency (%) | Surface pH | |
|---|---|---|---|---|---|---|---|
| 400 nm | 600 nm | ||||||
| Drug-Free Films | |||||||
| A | CHI 100 | 0.07 ± 0.01 | 33.41 ± 1.52 | >300 | 85.6 | 89.8 | 4.06 ± 0.37 |
| B | CHI/POZ 80:20 | 0.08 ± 0.02 | 33.67 ± 2.51 | >300 | 87.5 | 89.4 | 4.02 ± 0.30 |
| C | CHI/POZ 60:40 | 0.06 ± 0.01 | 35.00 ± 4.36 | <300 | 88.2 | 89.9 | 4.08 ± 0.33 |
| D | CHI/POZ 40:60 | 0.05 ± 0.01 | 33.33 ± 2.08 | <300 | 88.5 | 89.7 | 4.14 ± 0.32 |
| Drug-Loaded Films | |||||||
| A1 | CHI 100 | 0.06 ± 0.01 | 35.25 ± 2.29 | >300 | 36.6 | 65.1 | 3.76 ± 0.49 |
| B1 | CHI/POZ 80:20 | 0.07 ± 0.01 | 32.70 ± 1.51 | >300 | 45.4 | 68.1 | 3.86 ± 0.22 |
| C1 | CHI/POZ 60:40 | 0.06 ± 0.01 | 36.45 ± 5.31 | <300 | 35.9 | 72.9 | 3.78 ± 0.42 |
| D1 | CHI/POZ 40:60 | 0.05 ± 0.01 | 38.83 ± 1.83 | <300 | 40.5 | 78.2 | 3.86 ± 0.22 |
| Samples | Chemical Composition (% v/v) | Diameter of Growth Inhibition Zone (mm) | |
|---|---|---|---|
| Staphylococcus aureus | Escherichia coli | ||
| Drug-Free Films | |||
| A | CHI (100) | 0 | 0 |
| B | CHI/POZ (80:20) | 0 | 17.3 ± 2.1*** |
| C | CHI/POZ (60:40) | 0 | 13.3 ± 2.1** |
| D | CHI/POZ (40:60) | 0 | 21.0 ± 2.0**** |
| Drug-Loaded Films (CF 0.1% w/v) | |||
| A1 | CHI (100) | 38.6 ± 1.3*** | 39.5 ± 1.9* |
| B1 | CHI/POZ (80:20) | 36.0 ± 1.9** | 40.1 ± 2.6** |
| C1 | CHI/POZ (60:40) | 38.6 ± 1.6*** | 42.5 ± 2.2*** |
| D1 | CHI/POZ (40:60) | 46.1 ± 1.7*** | 39.3 ± 2.3* |
| E | Disc with CF | 31.2 ± 0.4 | 35.1 ± 1.2 |
© 2020 by the authors. Licensee MDPI, Basel, Switzerland. This article is an open access article distributed under the terms and conditions of the Creative Commons Attribution (CC BY) license (http://creativecommons.org/licenses/by/4.0/).
Share and Cite
Abilova, G.K.; Kaldybekov, D.B.; Irmukhametova, G.S.; Kazybayeva, D.S.; Iskakbayeva, Z.A.; Kudaibergenov, S.E.; Khutoryanskiy, V.V. Chitosan/Poly(2-ethyl-2-oxazoline) Films with Ciprofloxacin for Application in Vaginal Drug Delivery. Materials 2020, 13, 1709. https://doi.org/10.3390/ma13071709
Abilova GK, Kaldybekov DB, Irmukhametova GS, Kazybayeva DS, Iskakbayeva ZA, Kudaibergenov SE, Khutoryanskiy VV. Chitosan/Poly(2-ethyl-2-oxazoline) Films with Ciprofloxacin for Application in Vaginal Drug Delivery. Materials. 2020; 13(7):1709. https://doi.org/10.3390/ma13071709
Chicago/Turabian StyleAbilova, Guzel K., Daulet B. Kaldybekov, Galiya S. Irmukhametova, Diara S. Kazybayeva, Zhanar A. Iskakbayeva, Sarkyt E. Kudaibergenov, and Vitaliy V. Khutoryanskiy. 2020. "Chitosan/Poly(2-ethyl-2-oxazoline) Films with Ciprofloxacin for Application in Vaginal Drug Delivery" Materials 13, no. 7: 1709. https://doi.org/10.3390/ma13071709
APA StyleAbilova, G. K., Kaldybekov, D. B., Irmukhametova, G. S., Kazybayeva, D. S., Iskakbayeva, Z. A., Kudaibergenov, S. E., & Khutoryanskiy, V. V. (2020). Chitosan/Poly(2-ethyl-2-oxazoline) Films with Ciprofloxacin for Application in Vaginal Drug Delivery. Materials, 13(7), 1709. https://doi.org/10.3390/ma13071709

